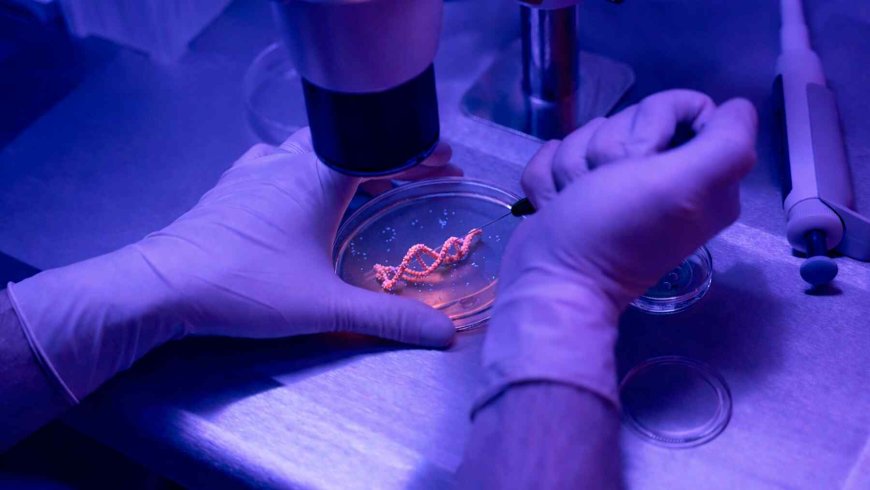
Scientists have discovered an ‘age counter’ in our DNA and now believe our aging process may have been miscalculated from the start

Scientists have discovered an ‘age counter’ in our DNA and now believe our aging process may have been miscalculated from the start
We may have been calculating the aging process incorrectly all along.
Science has developed a world of methods to accurately determine how we age and how fast this process takes place. However, an eye-opening study may have proven that the methods used over the past few decades were inaccurate, as a new ‘age counter’ has been discovered in our DNA.
What has led to the discovery of this new ‘age counter’ deep inside our cells?
How humanity has been able to study our DNA over the past few decades
The mysteries that reside deep within human DNA have become far easier to understand in recent years.
Between 1990 and 2003, the world came together to map the entire human genetic code. The Human Genome Project brought together a massive international effort that now acts as the reference map for all modern DNA research.
Before that, reading and decoding DNA was exceedingly expensive and took years.
Around the mid-2000s, next-generation sequencing revolutionized our ability to study DNA. NGS technology enabled scientists to sequence millions of fragments of DNA simultaneously, drastically reducing the costs and time frame for this process.
Studying the world of human DNA has led to astonishing developments
Our scientific ability to study the very building blocks of human life has shifted over the past three decades as new technology emerges from around the world.
The discovery of the CRISPR-Cas9 gene editing tool enabled scientists to not only study DNA, but to actually “edit” it. By effectively turning specific genes on and off, we now have a far clearer picture of what specific genes do inside our cells.
Since then, we have made several remarkable discoveries about human beings.
Such as the discovery of a calorie-burning switch inside each individual cell of fat in our bodies. However, as the scientific study of DNA is still relatively new, there is still so much more to uncover deep inside human cells.
Our DNA is the determining factor for a wide range of human traits that have puzzled science for decades.
For instance, we have come to learn that our DNA lineage plays a key role in some of us being able to handle cold weather better than our neighbors. So what is left for science to study in our DNA?
A recent study, “An evolutionary medicine and life history perspective on aging and disease: Trade-offs, hyperfunction, and mismatch,” published in Evolution, Medicine, and Public Health, has a few answers.
As humans, we are prone to making mistakes regarding science
As our technology progresses, we have learnt that some of our data may be incorrect.
For example, many of us believe that closing our eyes helps us to concentrate. However, discoveries have proven this action to be counterproductive and actually make “drowning out the noise” of the world more difficult.
Human DNA is complex and amazing, and we are only recently beginning to understand how our individual cells behave deep inside our DNA.
Study reveals that we have been calculating age incorrectly for decades
The aforementioned study has found that DNA methylation actually acts as an “age counter”, which determines our biological age as opposed to our chronological one.
The study has indicated that once this “age counter” reaches a specific threshold, our cells are damaged rapidly.
This suggests that our traditional age measurements have perhaps been focused on the wrong aspect. This hyperfunction of cells points to an imbalance in our cells’ ability to actively repair themselves, reversing decades of previous data sets.
We know that our DNA has a “sleeping” alarm system in each individual cell, but this study has found that the manner in which we calculate our age may have been far off.
What's Your Reaction?
 Like
0
Like
0
 Dislike
0
Dislike
0
 Love
0
Love
0
 Funny
0
Funny
0
 Angry
0
Angry
0
 Sad
0
Sad
0
 Wow
0
Wow
0














































